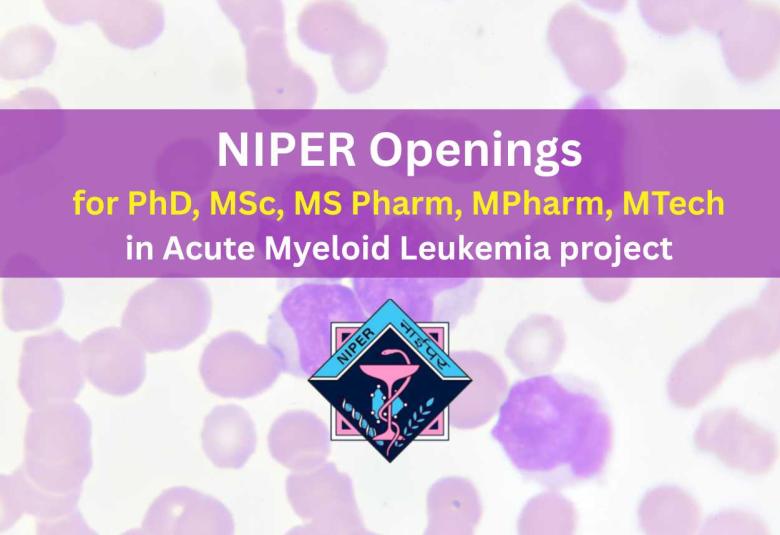
NIPER Openings : for PhD, MSc, MS Pharm, MPharm, MTech in Acute Myeloid Leukemia project

NIPER Opens for Pharmacy, Organic Chemistry, Medicinal Chemistry research in Acute Myeloid Leukemia
PhD with First-class M.Sc / M.S. Pharm. / M.Pharm / M.Tech Pharm. or an equivalent degree in Organic Chemistry, Medicinal Chemistry, Pharmaceutical Chemistry, or a closely related discipline.